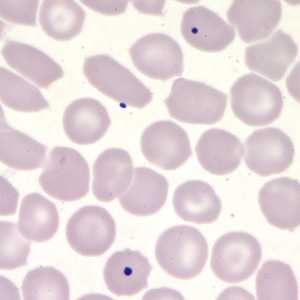
Case203

Case #203 - May, 2007
Giemsa-stained thick and thin blood smears were examined as part of a screening protocol for refugees from a country that has areas of ongoing malaria transmission. Figures A and B were captured from the thick smear; Figures C and D were captured from the thin smear. What is your diagnosis? Based on what criteria?

Figure A

Figure B

Figure C
Figure D
Case Answer
This was a case of balantidiasis caused by Balantidium coli, one of the largest protozoa that can parasitize humans. Usually these organisms can be identified at either 100× or 200× magnification. Diagnostic features were:
- the presence of cilia. If cilia are not visible, the organism may be mistaken for an artifact or possibly a helminth egg.
- an oval shape with the anterior end being somewhat tapered.
- a large, round contractile vacuole (black arrow, Figure A). In the captured plane of focus, the kidney bean shaped macronucleus and the cytostome (located on the anterior end) cannot be seen.

Figure A

Figure B
More on: Artifacts
Images presented in the monthly case studies are from specimens submitted for diagnosis or archiving. On rare occasions, clinical histories given may be partly fictitious.
DPDx is an education resource designed for health professionals and laboratory scientists. For an overview including prevention and control visit www.cdc.gov/parasites/.
- Page last reviewed: August 24, 2016
- Page last updated: August 24, 2016
- Content source:
- Global Health – Division of Parasitic Diseases and Malaria
- Notice: Linking to a non-federal site does not constitute an endorsement by HHS, CDC or any of its employees of the sponsors or the information and products presented on the site.
- Maintained By:


 ShareCompartir
ShareCompartir